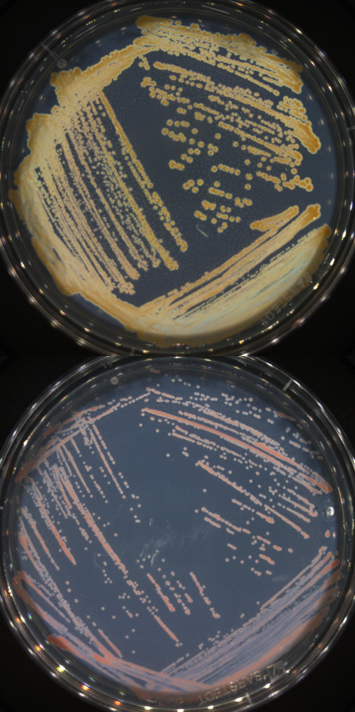

Angélique Rat
microbiologie
« Partir à l’étranger, tout comme le métier de chercheur, c’est nourrir sa curiosité, car chaque jour apporte son lot de découvertes, mais c’est aussi oser se détacher de ses repères et ainsi gagner en confiance en soi »

Spécialité : comprendre les mécanismes des interactions plantes-microbes pour développer des stratégies alternatives aux produits phytosanitaires, innovantes et durables.
Angélique a la bougeotte, sa carrière de jeune chercheuse en témoigne. Autriche, Belgique, Etats-Unis… elle s’est formée partout et dans les meilleures conditions contribuant ainsi à forger sa méthodologie, son ouverture d’esprit et sa confiance en soi. Et pourtant, le monde de la recherche était bien loin de ses préoccupations lorsqu’elle s’est orientée vers la biologie, son dada, au sein d’une classe prépa BCPST épanouissante. C’est au cours de des études d’ingénieur en agronomie qui ont suivi qu’elle s’est rendue compte que le cursus ne lui convenait pas ; au-delà de l’aspect technique, elle avait besoin de comprendre en profondeur les mécanismes biologiques du vivant. Elle s’accroche malgré tout, profitant de ses stages à l’étranger et d’un Erasmus pour approfondir ses connaissances et nourrir peu à peu son envie naissante de faire carrière dans la recherche, quitte à partir encore. Désireuse de se lancer dans une thèse, elle se porte candidate à différents projets en France et à l’étranger et c’est ainsi qu’elle est sélectionnée sur un projet Marie Curie, un dispositif européen qui permet de financer des travaux de recherche en favorisant fortement la mobilité. Elle atterrit ainsi dans le laboratoire de biochimie et de biotechnologies de l’université de Gand où elle gagne en connaissances et en compétences dans un environnement collaboratif stimulant nourri de mobilités entrantes et sortantes entre les différents étudiants du projet, et de partages. Son doctorat en poche, elle s’envole pour New-York où elle enchaîne avec un post-doctorat davantage porté sur l’écologie, et lui aussi incluant des mobilités entrantes et sortantes avec les collaborateurs du projet, qui lui sera tout aussi bénéfique et formateur : « La mobilité, c’est enrichissant tant sur le plan personnel que professionnel ». De retour en France, elle est recrutée sur une chaire de professeur junior proposée par le laboratoire RIBP de l’URCA. Un poste qui lui permet de poursuivre ses activités sur les interactions microbes-plantes et de porter des projets prometteurs, forte de ses multiples expériences professionnelles. Que peut-on lui souhaiter de plus ?
Parcours express
1. Classe préparatoire scientifique (2014)
2. Ecole d'ingénieur - Agrosup à Dijon (2017)
3. Doctorat à Gand en Belgique (2021)
4. Post-doctorat à New-York aux Etats-Unis (2023)
5. Chaire de professeur junior - RIBP/URCA Ã Reims (depuis 2023)